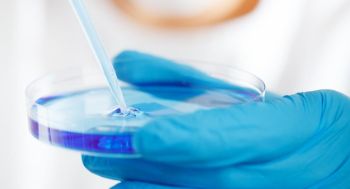
Heiliges Wasser löst Cholera-Fälle in Bad Kreuznach aus

Mehrere Cholera-Fälle in Bad Kreuznach sind auf sogenanntes „heiliges Wasser“ aus Äthiopien zurückzuführen. Das haben Ermittlungen des Gesundheitsamtes ergeben. Zuerst berichtete die Allgemeine Zeitung.
Im Februar wurden drei mit Cholera infizierte Patienten in Bad Kreuznacher Krankenhäusern behandelt, einer davon auf der Intensivstation. Die seltene Erkrankung wurde zunächst nicht erkannt, da Cholera in Europa kaum noch vorkommt.
Schnell stellte sich heraus, dass alle Betroffenen aus Äthiopien stammten. Zwei Männer hatten nach einer Reise zu einem Wallfahrtsort in ihrem Heimatland Kanister mit Wasser aus der Bermel-Giorgis-Quelle mitgebracht und an Landsleute verteilt. Laboruntersuchungen ergaben, dass das Wasser mit Cholera-Bakterien verunreinigt war. Auch die Stuhlproben der Patienten bestätigten dies.
Das Gesundheitsamt informierte umgehend nationale und internationale Stellen, darunter das Robert-Koch-Institut und die Weltgesundheitsorganisation. Parallel wurden in London vier weitere Cholera-Fälle bekannt, die ebenfalls auf das Wasser aus derselben Quelle zurückgeführt werden konnten. Die beteiligten Gesundheitsbehörden veröffentlichten die Erkenntnisse gemeinsam in einer Fachzeitschrift.
In einer Wohnung in Bad Kreuznach entdeckten Mitarbeiter des Gesundheitsamtes weitere Kanister des verseuchten Wassers, die anschließend fachgerecht entsorgt wurden. Alle sieben Erkrankten – drei in Bad Kreuznach und vier in London – haben die Infektion überstanden und gelten inzwischen als genesen.